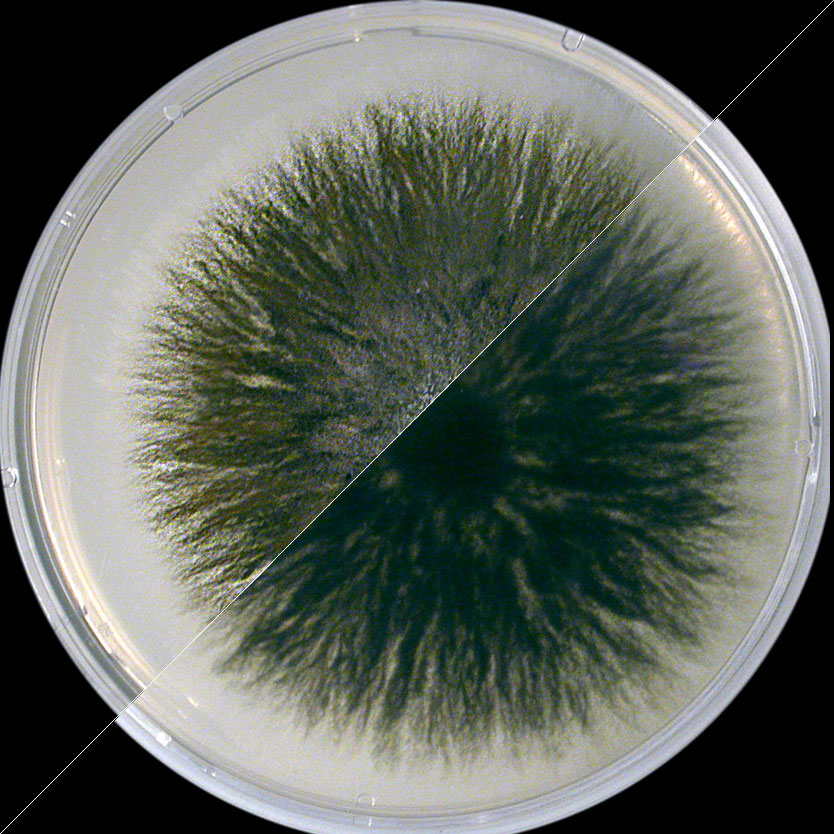
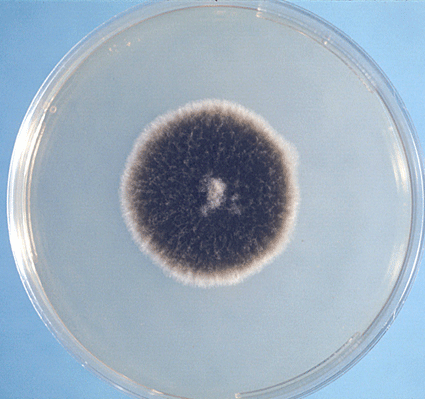

Alternaria alternate
Принц на белой шконке шоу ждули костек
Пруток амг3
Бережное отношение к традиции
Полтава краткое содержание аудио
Составные сочинительные союзы список
Как заполнить миграционную карту в тайланд
Что такое конц конца
Avowed системные требования
Маркировка кабеля пример
Она оно на пианино
Аксессуары для бассейнов в москве
Василенко историческая грамматика
Текст песни я хочу быть твоей
Alternaria alternate 104 фотографий